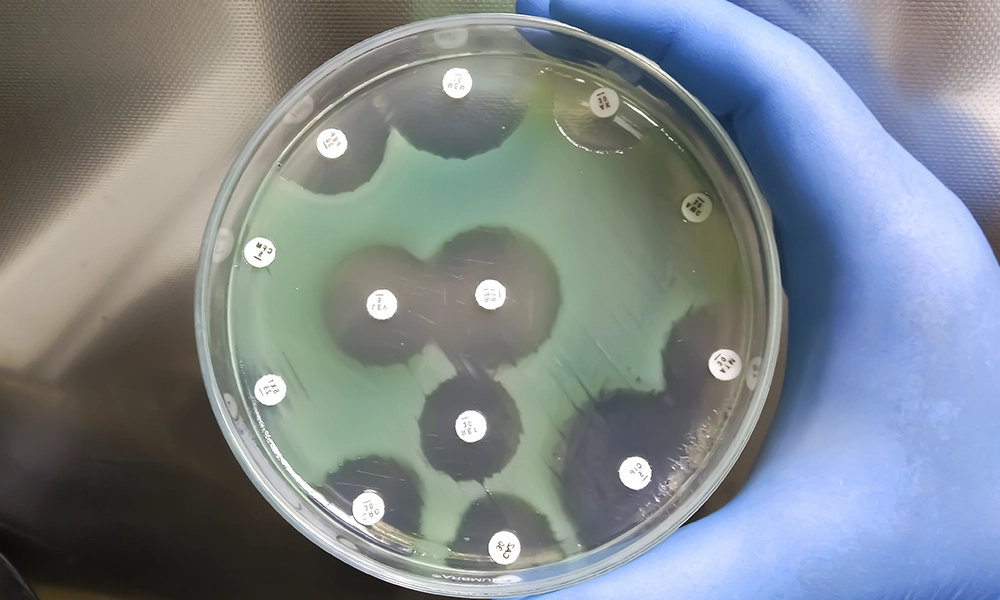
Media

Solving Critical Challenges with Point-of-Care Diagnostics

STIs (Sexually Transmitted Infections)
Rapid, reliable testing to reduce the spread of STIs.
AMR (Antimicrobial Resistance)
Supporting targeted treatment with precision diagnostics to tackle AMR.
Explore Our Cutting-Edge Platforms and Assays
Our innovative diagnostic solutions will include advanced platforms and a novel range of assays, designed to meet your needs.

Q-POC
Clear, simple test results by sophisticated software algorithms, removing any complicated interpretation of the result.

Assays
Explore our comprehensive range of assays, supporting rapid, multiplex diagnostics for STIs, AMR, and more.
Partner with Us to Innovate and Transform Diagnostics
At QuantuMDx, our mission is to make transformative diagnostic technologies accessible to everyone. We are continuously looking to work with others who share our passion and with whom we can develop innovative solutions for improving global health.
Key Benefits of Collaboration:
- Accelerated time-to-market.
- Customised solutions for your needs.
- Access to an established global network.
The Latest Insights and Publications from QuantuMDx
World AMR Awareness Week 2024
World AMR Awareness Week (WAAW), occurring 18-24 November every year, is a global awareness campaign that aims to improve understanding of antimicrobial resistance (AMR). It acts as a platform to share resources and evidence of best practice among One Health...
World Patient Safety Day 2024 – How the Q-POC Platform Supports Patient Safety
World Patient Safety Day is an annual global awareness campaign, led by the World Health Organization (WHO), that emphasises the importance of improving healthcare practices to prevent harm to patients. World Patient Safety Day 2024 The theme of World Patient Safety...
A guide to the UN General Assembly High-Level Meeting on Antimicrobial Resistance 2024
Antimicrobial resistance: A global threat Antimicrobial resistance (AMR) occurs when pathogens (e.g. bacteria, viruses, fungi, and parasites) that cause infections no longer respond to the drugs used to treat them, an issue that poses a significant global public...
The Next Pandemic: Q-POC and Disease X
The recent COVID-19 pandemic was a humanitarian and economic disaster, directly contributing to at least three million deaths and costing as much as US$15.8 trillion1. The pandemic also had many indirect effects on our health, with routine operations and medical...
Microarray-Based Technologies in Molecular Diagnostics: A Review
Microarray technologies have the potential to add significant value to the field of clinical diagnostics. This powerful technology is high-throughput and sensitive, allowing for the rapid screening of many genetic markers in parallel. In this blog post, we explore how...
QuantuMDx awarded Outstanding Achievement Award at Medilink Healthcare Business Awards 2024
QuantuMDx are delighted to have been awarded the Outstanding Achievement Award sponsored by Abacus at the 2024 Medilink Healthcare Business Awards. This award was for the Q-POC point of care PCR platform. It was a great evening with some truly inspiring stories....
Regulatory Challenges in Molecular Diagnostics: An Overview
Working in Regulatory Affairs is never boring. We’re in a space where the ground is shifting beneath our feet and not just little tremors - the whole landscape is in flux. The changes are greatest in Great Britain and Europe but, the advantage is that these things...
The Benefits of Rapid Diagnostics at the Point of Care
Throughout human history, infectious diseases have been a major cause of suffering and mortality. Remarkably, it was once suggested that half of all humans who have ever lived have been killed by malaria [1]. Equally incredibly, this may represent the tip of the...
Great North Research Conference
QMDx attended the Great North Research Conference recently. This was the first conference organised by NIHR to bring together academics and commercial companies within the North of England, to celebrate their achievements and showcase their expertise to allow for...
Transforming Point-of-Care Molecular Diagnostics at GIS23 Summit
We are delighted to share another achievement for QuantuMDx, and the North-East, within the molecular diagnostics space. On November 27th, 2023, QuantuMDx was invited to participate in the Global Investment Summit 2023 at Hampton Court Palace. This exclusive event...
Multiplex PCR and Infectious Disease Diagnosis
Polymerase chain reaction (PCR) is a widely-used technique in molecular biology. Thanks to the COVID-19 pandemic, the general public has become far more aware of PCR and its use in molecular diagnostics. In this blog, we will describe the information that can be...
Diagnosing Influenza at the Point of Care
Influenza, or ‘flu', is a common respiratory infection usually associated with a seasonal increase during the winter months - often referred to as 'flu season'. There are estimated to be around 1 billion cases annually, with more severe symptoms for those at higher...
The Clinical Impact of Rapid Multiplex PCR Testing Respiratory Viruses
As we enter the long anticipated period of summer holidays, it may seem premature to be thinking about winter planning but this is exactly what our colleagues in the NHS are doing. Through the months of October to March, winter planning aims to boost capacity and...
The Rise of Multi-Drug Resistant Gonorrhoea
Earlier this year (19 January 2023), the United States reported its first two cases of gonorrhoeal infection that had a reduced likelihood of responding to antibiotics. Even though gonorrhoeal infections are rarely life-threatening, this short post describes...
Health & Safety in laboratories
In my role as Laboratory Operations Manager at QuantuMDx, I am responsible for managing our suite of laboratories and Health and Safety. The safety and wellbeing of our staff is a priority at QuantuMDx and I have a multi-disciplined team of Representatives of Employee...
World Immunisation Week 2023
The Big Catch-Up World Immunisation Week aims to raise awareness of vaccine-preventable diseases and encourage collaborative action to strengthen immunisation programmes and protect against disease throughout all stages of life. The theme for 2023 is ‘The Big...
Point of Care Testing & the Future of Public Health
If the past three years have taught QuantuMDx anything, it would be to prepare for the unexpected. While it can be difficult to predict which infectious disease will emerge as ‘the next big thing’, surveillance tools map the occurrence and transmission of certain...
International Day of Women and Girls in Science Day 2023
International Day of Women & Girls in Science supports full and equal access to and participation in science for Women and Girls along with gender equality and female empowerment. QuantuMDx have conducted interviews with women holding scientific roles across...
The Relationship Between HPV and Cervical Cancer
Human papillomavirus (HPV) is the leading cause of cervical cancer. In this short post, which coincides with Cervical Cancer Prevention Week (23-29 January 2023), find out more about how HPV can cause cancer, the significance of different HPV subtypes in the...
QuantuMDx receives CTDA approval for sale of Q-POC™
NEWCASTLE UPON TYNE, UK 13 December, 2022. QuantuMDx Group Limited (“QuantuMDx”), today announces that its Q-POC™ SARS-CoV-2, Flu A/B & RSV Assay, has been approved for sale in the UK under The Medical Devices (Coronavirus Test Device Approvals) (Amendment)...
The Role of RSV in the Burden of Respiratory Tract Infections
SARS-CoV-2, the causative agent of COVID-19, and influenza are two well-known respiratory viruses, but what do you know about RSV (Respiratory Syncytial Virus)? Here, Carolyne Horner, Medical Scientific Liaison, describes aspects of RSV acute respiratory infection...
World Antimicrobial Awareness Week 2022
Preventing Antimicrobial Resistance Together Antimicrobial resistance (AMR) describes the situation when microorganisms (bacteria, fungi, parasites and viruses) no longer respond to the drugs (antimicrobials) that are used to treat infections. As a consequence,...
QuantuMDx & Menarini Announce Exclusive Distribution Agreement
Agreement will initially cover the UK and France with potential to expand to other European countries and worldwide NEWCASTLE UPON TYNE, UK, 2 November 2022. QuantuMDx Group Limited (“QuantuMDx”), a UK-based developer of transformational Point of Care molecular...
QuantuMDx & Sansure Biotech Enters into Agreement
The agreement sets a roadmap for the commercialisation of Q-POC™ and its assays in China The two companies will collaborate to accelerate the development of new assays on the Q-POC™ platform Offers potential for component sourcing and manufacturing optimisation...
Combined threats of the up-and-coming flu season
This article has been guest written by our CFO, Martin Walton. We have all recently witnessed at very close quarters the fact that not only has SARS-COV-2 not gone away, but it is also very much in the ascendant again. Many people have been laid low in recent weeks -...
QuantuMDx announces webinar: Rising to the challenge
Diagnosing, treating and managing respiratory infections NEWCASTLE UPON TYNE, UK, 5 July 2022. QuantuMDx Group Limited (“QuantuMDx”) will be offering insights and advice on tackling respiratory infections in the wake of the pandemic during a webinar later this month....
QuantuMDx Shortlisted for SelectScience Clinical Scientists Awards
NEWCASTLE UPON TYNE, UK, [17 June 2022. QuantuMDx Group Limited (“QuantuMDx”), a UK-based developer of transformational Point of Care diagnostics, is pleased to announce that Q-POC™ has made the SelectScientists’ Choice Awards shortlist for the Best New Clinical...
Elaine Warburton OBE Wins InspiringFifty Europe 2022 Award
NEWCASTLE UPON TYNE, UK, 14 June 2022. QuantuMDx Group Limited (“QuantuMDx”), a UK-based developer of transformational Point-of-Need diagnostics, is pleased to announce that its Co-Founder and former CEO Elaine Warburton OBE, has been recognised as one of the top 50...
QuantuMDx Special Recognition at the 2022 Med-Tech Innovation Awards
NEWCASTLE UPON TYNE, UK, [9] June 2022. QuantuMDx Group Limited (“QuantuMDx”), a UK-based developer of transformational point-of-care diagnostics, is pleased to announce that it has won the Special Recognition Award (Response to Covid-19)] at the Med-Tech Innovation...
QuantuMDx launches New PCR Respiratory Panel
New multiplex panel can detect SARS-CoV-2, Flu A, Flu B & RSV at the Point of Care Accurate PCR results delivered in approximately 30 minutes NEWCASTLE UPON TYNE, UK, 26 May 2022. QuantuMDx Group Limited (‘QuantuMDx’ or the ‘Company’), a UK-based...
QuantuMDx wins MediLink Award 2022
NEWCASTLE UPON TYNE, UK, [13] May 2022. QuantuMDx Group Limited (“QuantuMDx”), is pleased to announce that it has won the Innovation Award at the Medilink Healthcare Business Awards 2022. The Innovation Award was awarded to the Company’s Q-POC™ platform, recognising...
Helping Healthcare Services to Cope with Respiratory Diseases
For the first time in three years, it appears we can look forward to a summer where we might feel more relaxed about respiratory viruses. Nonetheless, healthcare services are bracing themselves for what might be an extremely challenging autumn and winter. After two...
New Website Launch
NEWCASTLE UPON TYNE, UK, 29 APRIL 2022. QuantuMDx Group Limited (“QuantuMDx”), is thrilled to announce the launch of a new website www.quantumdx.com/. Our new website features improved functionalities and easy access to essential information about our solution and our...
QuantuMDx wins two Bionow Awards 2021
NEWCASTLE UPON TYNE, UK, 01 APRIL 2022. QuantuMDx Group Limited (“QuantuMDx”), is pleased to announce that it has won two Bionow Awards 2021, which took place last night, Thursday 31 March 2022. The company was shortlisted for three awards, winning two in total. The...
QuantuMDx Wins Made in North East Medical Life Sciences Award 2022
NEWCASTLE UPON TYNE, UK, 25 MARCH 2022. QuantuMDx Group Limited (“QuantuMDx”), is pleased to announce that it has won the Medical Life Sciences award at the Made in North East Awards 2022. The Made in North East Awards applaud quality products and services that...
SARS-CoV-2 RT-PCR Detection Assay receives CTDA legislation approval
NEWCASTLE UPON TYNE, UK, 10 MARCH 2022. QuantuMDx Group Limited (“QuantuMDx”), today announces that its SARS-CoV-2 RT -PCR detection assay, has been approved in the UK under the UK Health Security Agency’s Medical Devices (Coronavirus Test Device Approvals)...
Martin Walton appointed as Chief Financial Officer
NEWCASTLE UPON TYNE, UK, 24 FEBRUARY 2022. QuantuMDx Group Limited (“QuantuMDx”), is pleased to announce the appointment of Martin Walton as Chief Financial Officer. Martin has over 35 years’ experience working within large global companies with the last 15...
Q-POC™ SARS-CoV-2 assay receives CTDA legislation approval
NEWCASTLE UPON TYNE, UK, 22 FEBRUARY 2022. QuantuMDx Group Limited (“QuantuMDx”), today announces that its rapid PCR SARS-CoV-2 test, with the multiplex Q-POC™ platform, has been approved for continued sales in the UK under the UK Health Security Agency’s Medical...
What could rapid Point of Need testing mean for the future of public health?
The last few years have felt long and have been difficult for most of us, thanks in no small part to the COVID-19 pandemic. Although it is beginning to feel like we’re through the worst of it, many people are acutely aware of the continuing risks to vulnerable people...
What are the benefits of adding LIS connectivity to a POC platform?
Last week QuantuMDx achieved yet another milestone by introducing Laboratory Information System (LIS) connectivity to the Q-POC™ software. The latest software release for the Q-POC™ platform, 3.2, is a significant upgrade that enables test records to be...
Are the new COVID-19 rules a mixed blessing for care homes?
We recently conducted a survey of how the demands of COVID-19 testing had impacted on UK care homes together with Care Home Professional magazine. What we found was shocking: the demands of COVID-19 testing has pushed homes to breaking point. Many staff told us...
QuantuMDx confirm its tests detect all known COVID-19 variants
NEWCASTLE UPON TYNE, UK, 26 NOVEMBER 2021. QuantuMDx Group Limited (“QuantuMDx”), today confirms that both its SARS-CoV-2 assays for open PCR platforms and its rapid PCR device, Q-POC™, as well as its future respiratory panel (SARS-CoV-2, Flu A, Flu B and RSV A/B),...
QuantuMDx investment from Vita Spring and future cooperation plans
Funds will be used to develop further multiplexing capabilities and menu expansion in collaboration with Sansure, on the Q-POC™ platform Cooperation Agreement to accelerate regional commercialisation of Q-POC™ and its cassettes in China and other South-East Asian...
QuantuMDx partners with Cignpost Diagnostics
Providing a rapid, PCR COVID-19 testing solution to the UK film & TV industry NEWCASTLE UPON TYNE, UK, 16 August 2021. QuantuMDx has announced it is partnering with Cignpost Diagnostics, (‘Cignpost’), a leading provider of COVID-19 workplace testing to the...
QuantuMDx launches Q-POC™ – a PCR diagnostic system
NEWCASTLE UPON TYNE, UK: QuantuMDx today announces the launch of Q-POC™ - a rapid, PCR point of care diagnostic system. Launching at ECCMID 2021, QuantuMDx’ Q-POC™ system and its first test, a SARS-CoV-2 detection assay, are now CE-IVD marked under the In Vitro...
QuantuMDx included on PHE Microbiology Framework
Diagnostic Goods and Services (Lot 1) Research and Development Goods (Lot 2) NEWCASTLE UPON TYNE, UK, 08 June 2021. QuantuMDx has been successful in both Public Health England (‘PHE’) tenders the Company applied for. QuantuMDx will be included in the Framework...
Mirre de Noo appointed as non-executive director
NEWCASTLE UPON TYNE, UK, 26 May 2021. QuantuMDx has appointed Mirre de Noo, as a Non-Executive Director. Mirre has over 20 years of experience in healthcare, strategy and innovation. As a life sciences and healthcare executive she has a track record of introducing and...
QuantuMDx completes £11m funding round
NEWCASTLE UPON TYNE, UK, 24th March 2021. QuantuMDx today announces it has raised £11 million in its latest funding round. Proceeds will be used to complete manufacturing and commercial scale up of Q-POC™, QuantuMDx’s rapid, PCR point of care diagnostic system...
Prime Minister, Boris Johnson visits QuantuMDx
NEWCASTLE UPON TYNE, UK, 13 February 2021. QuantuMDx today welcomed the Prime Minister, Rt Hon Boris Johnson MP, for a tour of its purpose-built HQ in Newcastle upon Tyne. QuantuMDx has developed Q-POC™ a revolutionary 30 minute PCR diagnostics device,...
Staff Spotlight: Andy Whittle
Andy Whittle, VP Manufacturing at QuantuMDx, discusses the highs and lows of scaling up to manufacture, during a global pandemic. What is your background? I've over 20 years manufacturing experience, focusing primarily within life science and medical devices. I...
Staff Spotlight: Sam Bhatt
Sam Bhatt is a Programme Manager at QuantuMDx. Here, Sam tells us more about himself and gives us an insight into his role. When did you start working at QuantuMDx? I joined the QuantuMDx team in May 2015, not long after I completed my PhD (in radiotracers for...
Get in touch with us
QuantuMDx Group Ltd.
Lugano Building
57 Melbourne Street
Newcastle upon Tyne
NE1 2JQ


















































